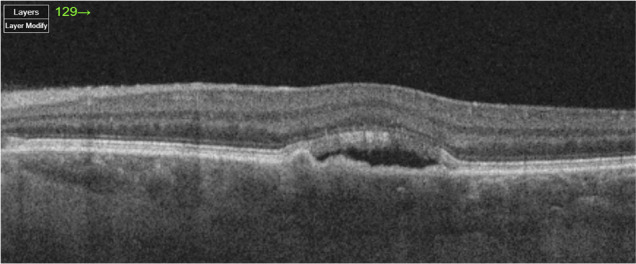

光学相干层析:简介。
Q4 Medicine
引用次数: 0
摘要
本文章由计算机程序翻译,如有差异,请以英文原文为准。

Optical coherence tomography: an introduction.
求助全文
通过发布文献求助,成功后即可免费获取论文全文。
去求助
来源期刊

Community Eye Health Journal
Medicine-Ophthalmology
CiteScore
0.60
自引率
0.00%
发文量
16
审稿时长
14 weeks
期刊介绍:
The Community Eye Health Journal is published by the International Centre for Eye Health, London School of Hygiene and Tropical Medicine, London. It addresses the elimination of avoidable blindness and focuses on countries where the burden of preventable blindness is greatest. Guided by the Global Initiative for the Elimination of Avoidable Blindness by 2020 - VISION 2020: the Right to Sight, the journal prioritises three key areas: disease control (with emphasis on VISION 2020 priority diseases such as cataract, childhood blindness, trachoma, refractive error and onchocerciasis) human resource development infrastructure and technology.
 求助内容:
求助内容: 应助结果提醒方式:
应助结果提醒方式:


